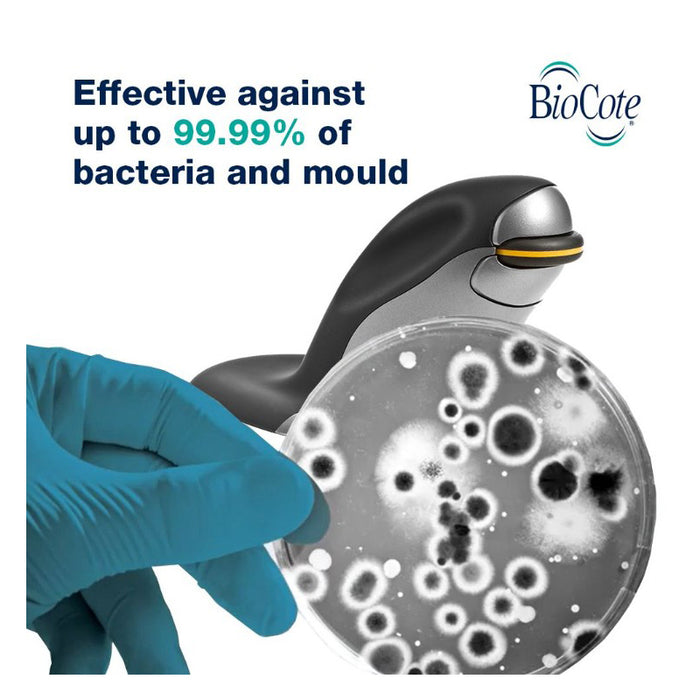

Penguin 3-in-1 molempikätinen pystyhiiri - L-koko
Tässä uudessa 3-in-1-mallissa ikonisesta ergonomisesta Penguin -hiirestä yhdistyvät langallinen, langaton ja Bluetooth-tekniikka yhdessä pingviinissä.
Penguin asettaa uudet standardit suojautumiselle erilaisia yläraajojen sairauksia vastaan, kuten toistuvan rasituksen aiheuttamia vammoja (RSI) ja rannekanavaoireyhtymä-oireyhtymää (CTS) vastaan, sillä se mahdollistaa oikean ja vasemman käden työtaakan jakamisen ja välttää rannenivelen liioiteltuja liikkeitä, jotka voivat lisätä painetta rannekanavan pehmytkudoksiin. Käsien säännöllinen vaihtaminen päivän mittaan auttaa ehkäisemään käsivarren ja olkapään staattista lihasjännitystä (SMS), joka on merkittävä epämukavuuden lähde hiirityössä.
BioCote®-antimikrobisella teknologialla varustettu Penguin -hiiri estää bakteerien kasvua, joten se sopii erinomaisesti jaettuihin työtiloihin ja hot desking -ympäristöihin.
Penguin -hiiri on saatavana kolmessa koossa, ja sen voi valita mittaamalla käden ranteen ensimmäisestä poimusta keskisormen kärkeen.
Koko-opas
- PIENI 0-16 cm (noin 0-6")
- KESKIKOKOINEN 16-18 cm (6-7” noin)
- LARGE 18 cm + (7” + noin)
Ominaisuudet
- Saatavana kolmea eri kokoa, jotka sopivat eri käsimittoihin
- Yhdistetty langallinen/langaton/bluetooth-tekniikka
- Pystysuora muotoilu edistää käden ergonomisempaa asentoa.
- Säädettävät DPI-asetukset (800, 1200, 1600 tai 2400) nopeaan ja tarkkaan kursorin liikutteluun.
- Tarkka vierityspyörä sujuvaan ja tarkkaan asiakirjan navigointiin
- Soft-touch-näppäimet, joissa on alhainen aktivointivoima ja täysi näppäinten liikerata mukavaa kirjoittamista varten.
- Päällystetty BioCote® antimikrobisella teknologialla, joka vähentää bakteereja jopa 99,99 %:lla
Tekniset tiedot
- Mitat (korkeus x leveys x syvyys): 95,3 x 173 x 196,9 mm.
- Tuotteen paino: 270 g
- DPI-asetukset: 800, 1200, 1600 ja 2400
- Yhteensopivuus: Mac OS X, Windows XP, Windows Vista, Windows 7, 8, 10, 11, Mac OS X
- Liitettävyys: USB 2.0
- Takuu: 2 vuotta
- Lataukset
-
Käyttöohje/User guide (english) Käytettävyystutkimus/Usability study (english) Mac autoscroll (english)